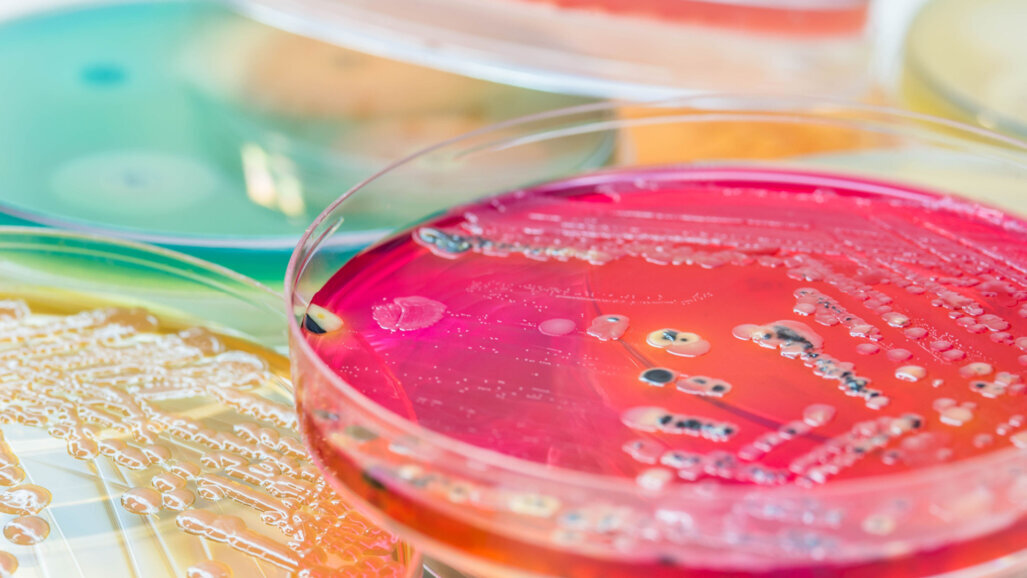
“Like bacteria hitch-hiking on the fungi”—study shows how organisms “walk” across teeth

PHILADELPHIA, US: A research team from the University of Pennsylvania has found that, within hours of growth, groupings of bacteria were able to “leap” more than 200 times their own body length across dental surfaces, offering an insightful explanation into the mechanism behind rapid bacterial colonisation and dental caries.
In a university press release, co-author Prof. Hyun (Michel) Koo, founding director of the Center for Innovation and Precision Dentistry at the university, stated that, although the organisms comprising the biofilm in the laboratory were non-motile, the combination of bacteria and fungi created a “superorganism”: an assemblage that was far more difficult to remove from teeth than either of its two constituents alone.
The research team was originally studying severe childhood caries in toddlers when they were shocked to find that the blend of bacteria and fungi actually developed the ability to “walk” and “leap”, when neither could do so before. The organisms in question, Streptococcus mutans and the fungus Candida albicans, were identified as the main components of the biofilm causing the severe caries in toddlers.
Dr Zhi Ren, a postdoctoral fellow working in the laboratory and one of the co-authors of the paper, utilised a form of microscopy that allowed the team to observe the changes in the organisms in real time. The bacteria and fungi were able to develop unexpected levels of adhesion and microbial tolerance. The fungi sprouted hyphae, which enabled the bacteria to better attach themselves and prevent removal.
Despite the secure attachment, the new assemblage was still able to move itself forward, “like bacteria hitch-hiking on the fungi,” said Prof. Koo. This ability meant that, once the assemblages were tested on human teeth in a laboratory model, the biofilm spread much faster than anticipated, because the organisms were able to move as they grew.
The findings could not only help dentists better understand the levels of prevention necessary to stave off severe caries, but could also help clinicians understand bacterial proliferation in other areas of medicine.
The study, titled “Interkingdom assemblages in human saliva display group-level surface mobility and disease-promoting emergent functions”, was published in the 11 October 2022 issue of the Proceedings of the National Academy of Sciences.
Tags:
TORONTO, Canada: Since the use of an antimicrobial oral rinse in intensive care units (ICUs) and its effectiveness in preventing pneumonia have been ...
As dental professionals, we have amazing opportunities to give back. Associations, organisations and academia promote and support the idea of giving back, ...
Petersilka et al. said: “If a new form of therapy is to be considered worth integrating into standard periodontal therapy, it either has to be superior in...
BOZEMAN, Mont., US: Montana State University (MSU) researchers have developed a 3D-printing device that is able to replicate microbial mosaics and thereby ...
Prof. Dr. Raphael Monte Alto
Live webinar
Mon. 22 June 2026
8:00 pm EST (New York)
Live webinar
Tue. 23 June 2026
1:00 pm EST (New York)
Live webinar
Tue. 23 June 2026
3:00 pm EST (New York)



 Austria / Österreich
Austria / Österreich
 Bosnia and Herzegovina / Босна и Херцеговина
Bosnia and Herzegovina / Босна и Херцеговина
 Bulgaria / България
Bulgaria / България
 Croatia / Hrvatska
Croatia / Hrvatska
 Czech Republic & Slovakia / Česká republika & Slovensko
Czech Republic & Slovakia / Česká republika & Slovensko
 France / France
France / France
 Germany / Deutschland
Germany / Deutschland
 Greece / ΕΛΛΑΔΑ
Greece / ΕΛΛΑΔΑ
 Hungary / Hungary
Hungary / Hungary
 Italy / Italia
Italy / Italia
 Netherlands / Nederland
Netherlands / Nederland
 Nordic / Nordic
Nordic / Nordic
 Poland / Polska
Poland / Polska
 Portugal / Portugal
Portugal / Portugal
 Romania & Moldova / România & Moldova
Romania & Moldova / România & Moldova
 Slovenia / Slovenija
Slovenia / Slovenija
 Serbia & Montenegro / Србија и Црна Гора
Serbia & Montenegro / Србија и Црна Гора
 Spain / España
Spain / España
 Switzerland / Schweiz
Switzerland / Schweiz
 Turkey / Türkiye
Turkey / Türkiye
 UK & Ireland / UK & Ireland
UK & Ireland / UK & Ireland
 Brazil / Brasil
Brazil / Brasil
 Canada / Canada
Canada / Canada
 Latin America / Latinoamérica
Latin America / Latinoamérica
 USA / USA
USA / USA
 China / 中国
China / 中国
 India / भारत गणराज्य
India / भारत गणराज्य
 Pakistan / Pākistān
Pakistan / Pākistān
 Vietnam / Việt Nam
Vietnam / Việt Nam
 ASEAN / ASEAN
ASEAN / ASEAN
 Israel / מְדִינַת יִשְׂרָאֵל
Israel / מְדִינַת יִשְׂרָאֵל
 Algeria, Morocco & Tunisia / الجزائر والمغرب وتونس
Algeria, Morocco & Tunisia / الجزائر والمغرب وتونس
 Middle East / Middle East
Middle East / Middle East

To post a reply please login or register